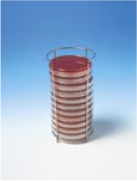
写真：シャーレラックにシャーレを積み重ねた例

7. 関連製品[アネロパック®]
嫌気指示薬(要冷蔵)

色の変化で酸素の有無がわかります

- 嫌気指示薬の色変化は可逆ですが、変色能力が徐々に低下しますので再使用はできません
- 嫌気指示薬のフィルムの窓には小さな針穴が開いています。この針穴からガスが透過しますので、錠剤をフィルムから取り出して使わないでください
- 無酸素状態にして必ず冷蔵庫に保存してください。使用中の残りは、すみやかに空気を追い出して密閉してください
- 有効期間は、冷蔵保存で6ヶ月です
シャーレラック
角型ジャー(標準型)用シャーレラック【ステンレス製】
- マイクロプレート、丸型・角型シャーレいずれにも使えます
- シャーレラックごとジャーへ収納。出し入れをまとめて1度で行えます
- 角型ジャー(標準型)専用の設計。ジャーにぴったり納まります
|
|
|
|---|
シャーレラックの収納内容
- 丸型シャーレ10枚
- 角型シャーレ、マイクロプレート5枚
スタンディングパウチ用シャーレラック
|
シャーレ12枚収納可能 |
シャーレを積み重ねた例 |
|---|
試験管立て[ステンレス製]
- 汚れに強く水洗いでき、耐久性に優れます
- Z字形でコンパクト。スペースを取りません
- 3列×4=12本までの試験管を立てられます
- 直径18mmまでの試験管に適用(開口径19mm)
|
|
角型ジャー(標準型)での使用例 |
|---|
密閉クリップ
|
通常用
|
高温培養用
|
|---|

![写真:試験管立て[ステンレス製]](/products/sc/anaeropack/img/kanren_ph_06.jpg)


